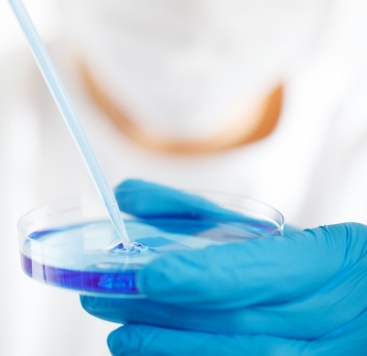

송도, 글로벌 바이오 R&D 허브로 도약 🚀🧬
🌍 바이오 클러스터 ‘업그레이드’…스타트업과 협력 강화
인천 송도가 단순한 의약품 위탁생산(CMO) 중심에서 벗어나, 연구개발(R&D) 협력 허브 로 변신하고 있습니다.
바이오 대기업과 스타트업 간 공동 연구개발 성과가 나오면서, 송도가 글로벌 바이오 혁신 거점 으로 주목받고 있습니다.
📍 주요 참여 기업:
- 셀트리온 → 오픈이노베이션 해외 확장
- SK바이오사이언스 → 글로벌 연구·공정개발(R&PD) 센터 건립
- 롯데바이오로직스 → 바이오 벤처 이니셔티브 추진
- 인천시·인천경제청 → 바이오 스타트업 지원 시설 확충



🔬 셀트리온, 오픈이노베이션 확장…스타트업과 ‘윈-윈’
셀트리온은 국내 스타트업과의 협력을 해외로 확대 하기로 했습니다.
✅ 스타트업 협력 사례:
- 바이오미 스타트업 → 미생물 생균 치료제 기술 인정, 지분 투자 결정
- 일부 스타트업 → 일본 KLSAP(간사이 라이프 사이언스 액셀러레이터) 프로그램 우승
- 스타트업 기술 활용 → 셀트리온의 FDA 임상시험 계획서 승인 지원
📢 셀트리온 관계자:
"공동개발과 네트워킹 지원을 통해 국내외 바이오산업 생태계의 선순환을 이끌겠다."



🏗️ SK바이오사이언스, 3천억 투자…글로벌 연구센터 건립
- 투자금액: 3,257억 원
- 부지: 송도 3만413㎡
- 완공 목표: 2024년 이후
- 기능:
- 바이오 전문 인력 양성
- 글로벌 바이오 기업·기관 연구 공간 제공
📢 SK바이오사이언스:
"바이오 R&D 경쟁력을 강화해 송도를 글로벌 바이오 허브로 만들겠다."



🏢 롯데바이오로직스, 바이오 스타트업 협력 ‘바이오 벤처 이니셔티브’ 추진
- 2034년까지 순차적 공장 준공
- 스타트업과 공동 연구개발 진행
📢 롯데바이오 관계자:
"생산 공장과 연계해 바이오 혁신 기업과의 협력을 강화할 것."

🏙️ 인천시·경제청, 바이오 협업 공간 ‘스파크 플렉스’ 조성
📌 사업 개요:
- 민간 자본 5,000억 원 유치
- 송도 국제업무단지 내 조성
- 개방형 혁신 공간(오픈이노베이션 센터) 구축
- 2025년 착공 예정
📢 인천경제청:
"바이오 기업 간 협력과 공유를 촉진하는 오픈이노베이션 공간이 될 것."



🔬 ‘K-바이오 랩허브’, 송도에 2028년 완공 예정
📌 사업 개요:
- 위치: 연세대 국제캠퍼스
- 총사업비: 2,726억 원
- 주관: 중소벤처기업부
- 기능:
- 바이오 스타트업 지원
- 산·학·연·병 협력 플랫폼 구축
📢 인천경제청:
"송도를 글로벌 바이오 창업 허브로 육성할 것."



🚀 송도, ‘바이오 메카’에서 ‘글로벌 R&D 허브’로!
📈 기대 효과:
✅ 글로벌 바이오 기업·스타트업 협력 강화
✅ 바이오산업 혁신 생태계 구축
✅ R&D 시설 확충 → 고급 인력 유치 및 산업 성장 가속화
📢 송도, 단순한 바이오 생산기지가 아닌, ‘혁신의 중심지’로 거듭납니다! 🔬🔥



강남 구룡마을 재개발 내용 구룡마을 재개발 총 가구수 구룡마을 미리 내 집 구룡마을 재개발 보
강남 마지막 판자촌 ‘구룡마을’, 자연 친화적 대단지로 변신 🚧🏡서울 강남의 마지막 판자촌이었던 구룡마을이 3520가구 규모의 대단지 주거단지로 탈바꿈합니다.서울주택도시공사(SH)는 구
eclipse.fingerplay.co.kr
카페 폭포 위치 영업시간 메뉴 할인 주차 할인 방법 명당자리 추천 메뉴
카페 폭포 소개카페 폭포는 서울 서대문구 연희로에 위치한 유명한 카페로, 홍제폭포를 배경으로 자연과 도시가 어우러진 특별한 풍경을 제공합니다. 이곳은 2023년 4월에 개장하여 140만 명 이상
eclipse.fingerplay.co.kr
남대문 갈치조림골목 원조 갈치조림 중앙식당 줄서는 식당 위치 주소 가는 방법 영업시간 주차
남대문 갈치조림 중앙식당 소개남대문 갈치조림 중앙식당은 서울 중구 남대문시장 내에 위치한 전통적인 갈치조림 맛집입니다. 이곳은 50년 이상의 역사를 자랑하며, 남대문시장 갈치조림골목
eclipse.fingerplay.co.kr


